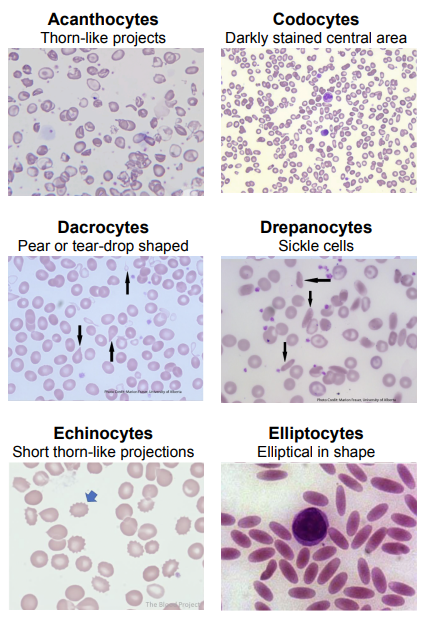
<p>Poikilocytosis <span data-name="drop_of_blood" data-type="emoji">🩸</span><span data-name="microscope" data-type="emoji">🔬</span></p>

1/155
Looks like no tags are added yet.
Name | Mastery | Learn | Test | Matching | Spaced |
|---|
No study sessions yet.
🩸 Blood
The only liquid connective tissue and makes up approximately 8% of our total body weight
⚖ Heavier
🌀 Thicker
💧 More Viscous
💉 Compared to Water, Blood is:? (in terms of weight, thickness and viscosity) [3]
🎯 B. The first statement is false. The second statement is true.
I. The body is mostly water, but blood is only a part of bodily fluids, not the majority.
I. The body is mostly made up of blood.
II. The body contains cells consisting of around 65-90% water by weight.
A. The first statement is true. The second statement is false.
B. The first statement is false. The second statement is true.
C. Both statements are true.
D. Both statements are false.
🚛 Transportation – Carries oxygen (O₂), carbon dioxide (CO₂), nutrients, and metabolic wastes throughout the body.
🌡 Regulating Body Temperature – Helps maintain and distribute heat.
⚖ Regulating pH – Acts as a buffer system to keep the body's pH balanced.
🩸 Functions of Blood [3]

55% Plasma (mostly water, proteins (albumin), electrolytes, dissolved gases)
top layer, least dense
<1% buffy coat (platelets and leukocytes)
smallest layer
45% erythrocytes
🩸 Blood components? [3]
🟡 Plasma (Top Layer)
[🩸 Blood Component]
📏 Tallest, top-most layer, and the least dense layer.
💦 Mostly water but contains proteins (albumin), electrolytes, and dissolved gases in the blood
🌬 The blood is involved in transferring oxygen and carbon dioxide
⚪ Buffy Coat (Middle Layer)
[🩸 Blood Component]
📉 Smallest layer (≈ 1% of blood).
🦠 Contains platelets & white blood cells (leukocytes).
🔴 Erythrocytes (Red Blood Cells) (Bottom Layer)
[🩸 Blood Component]
⚖ Most dense layer.
🩸 Makes up 45% of blood.
🏆 Responsible for oxygen transport.
centrifugation 🧪
🔬To see blood components, ________ is used, separating layers by density.
Plasma 🩸💛
📌 The yellowish liquid component of blood, making up ~55% of total blood volume.
💦 Composition:
🌊 91.5% Water
🧪 8.5% Solutes (Proteins & Other Substances)
Hepatocytes, albumin, globulins, fibrinogen
🏥 Albumin, Globulins, Fibrinogen (produced by hepatocytes).
🩸 Fibrinogen – Plays a key role in blood clotting & wound healing.
🦠 Antibodies/Immunoglobulins – Provide immunity.
⚡ Electrolytes, Nutrients, Enzymes, Hormones
🚮 Waste Products (Urea, Ammonia, Metabolites)
📂 Plasma Proteins & Solutes [4]
Red Blood Cells 🩸
White Blood Cells 🦠
Platelets 🩹
🔬 Formed Blood Elements? [3]
🔬Hemopoiesis
📌 The formation, development, and maturation of formed blood elements in the bone marrow.
Red Blood Cells (RBCs / Erythrocytes) 🩸
[What type of Formed Elements?]
🌬 Transport oxygen (O₂) from lungs to tissues and carry carbon dioxide (CO₂) back to lungs for exhalation.
🔄 Biconcave shape for flexibility and gas exchange.
🚫 Lacks a nucleus (anucleated) to maximize space for hemoglobin.
🟥 Red color due to hemoglobin
😲 A. The first statement is true. The second statement is false.
II. WBCs are larger than RBCs
I. Hemoglobin is the one responsible for the red color of Red Blood Cells.
II. RBCs are larger than WBCs
A. The first statement is true. The second statement is false.
B. The first statement is false. The second statement is true.
C. Both statements are true.
D. Both statements are false
White Blood Cells (WBCs / Leukocytes) 🦠
[What type of Formed Elements?]
🛡 Contributes to the immune system by defending the body against infections and foreign invaders
🧬 Contain a nucleus, unlike RBCs.
❌ Lack hemoglobin and are larger than RBCs.
Platelets (Thrombocytes) 🩹
[What type of Formed Elements?]
🏥 Plays a crucial role in blood clotting by forming a plug at the site of a vascular injury
🧩 Small, cell fragments without a nucleus.

🧬 1. Pluripotent Stem Cell (Hemocytoblast)
🍼 Immature, undifferentiated cells.
📍 Found in bone marrow.
🔄 Undergo differentiation to become specialized blood cells.
🔀 Develop into Myeloid Stem Cells and Lymphoid Stem Cells.
🔴 2. Myeloid Stem Cells
🏠 Develop in red bone marrow.
🛠 Differentiate into progenitor cells or precursor cells.
⚙ 3. Progenitor Cells
🚫 Can no longer reproduce.
🎯 Committed to forming specific blood elements like RBCs & platelets.
🔬 4. Precursor Cells ("-blasts")
📌 Further differentiate into formed blood elements.
🦠 Example: Monoblasts → Monocytes.
🦠 5. Lymphoid Stem Cells
🏠 Start in red bone marrow, but finish development in lymphatic tissue.
⚔ Differentiate into lymphocytes (key immune cells).
😲 Process of Hemopoiesis or Differentiation [5]
![<p><span data-name="astonished" data-type="emoji">😲</span> Process of Hemopoiesis or Differentiation <strong>[5]</strong></p>](https://knowt-user-attachments.s3.amazonaws.com/9ec49be0-f4f8-4544-8cda-db28c267fe4a.png)
✅ B. Hemocytoblasts
✅ A. Lymphoid stem cells
❌ False!
✅ True
PRACTICE TEST 😄
❓ What are pluripotent stem cells also known as?
A. Lymphoblasts
B. Hemocytoblasts
C. Progenitor cells
D. Myeloblasts
❓ Which stem cell type matures in the lymphatic tissue?
A. Lymphoid stem cells
B. Myeloid stem cells
C. Progenitor cells
D. Precursor cells
💡 True or False: Progenitor cells can reproduce themselves and differentiate into any blood cell.
💡 True or False: Myeloid stem cells differentiate into progenitor cells, while lymphoid stem cells give rise to lymphocytes.
Erythropoietin 🩸
Thrombopoietin 🩹
Cytokines 🦠
🔬 Hemopoietic Growth Factors [3]
🩸 Erythropoietin (EPO)
[Hemopoietic Growth Factor 🔬]
📌 Stimulates RBC production (erythropoiesis) in red bone marrow.
💉Used to treat anemia particularly in conditions like:
chronic kidney disease (CKD)
cancer (chemotherapy can damage blood cells)
or other disorders that reduce RBC count
🩹 Thrombopoietin (TPO)
[Hemopoietic Growth Factor 🔬]
📌 Regulates growth & maturation of megakaryocytes(cells that give rise to platelets)
💉 Clinical Use: Helps patients with low platelet counts.
🦠 Cytokines
[Hemopoietic Growth Factor 🔬]
📌 Have the responsibility of regulation and maturation of blood cells in the bone marrow
🔴 Erythrocytes
📌Also known as Red Blood Cells (RBCs)
🩸 are made in red bone marrow through erythropoiesis.
📊 Normal RBC Count:
♂ Males – 5.4 million per µL of blood.
♀ Females – 4.8 million per µL of blood.
🚫 Anucleated
no nucleus
all their internal space is available for oxygen transport
🔄 Biconcave shape
much greater surface area than spheres, to facilitate oxygen transport
🟥 Red color due to hemoglobin
🧬 Characteristics of Erythrocytes [3]
Lower RBC count for females is associated with menstruation
😲 Why there are lower RBC count for females compared to males?

📌 Occurs in the red bone marrow.
🛠 Stages of Erythropoiesis:
🌱 Pluripotent hematopoietic stem cell will differentiate into proerythroblast (pronormoblast), then it will develop into erythroblast (normoblast).
Once it undergoes 🧬erythroblast, it will lose its nucleus and some organelles to form 🔄reticulocyte (type of cell directly before erythrocyte).
Once it forms into 🔄reticulocytes, it will be transported to the blood.
The process from reticulocytes to erythrocyte usually happens 1-2 days after it is released from the red bone marrow.
Because it loses its nucleus, that is the reason why it becomes biconcave. It starts forming its biconcave shape after losing its nucleus.
📌 Key Feature – RBCs lose their nucleus, which allows them to become biconcave for better gas exchange and flexibility.
🔬 Erythropoiesis Process (RBC production and maturation)

✅ A – Reticulocytes lose their nucleus before entering the blood, while erythrocytes are anucleated (lack a nucleus) to maximize hemoglobin capacity.
I. 🩸 Reticulocytes lose their nucleus before entering the bloodstream.
II. 🧬 Erythrocytes retain their nucleus to help in oxygen transport.
A. The first statement is true. The second statement is false.
B. The first statement is false. The second statement is true.
C. Both statements are true.
D. Both statements are false.
When it loses its nucleus ! 😲
When does forming of biconcave occur? 😲

B2, B1, a2, a1
Hemoglobin has the responsibility to transport CO2
releases Nitric Oxide (NO) that helps cause vasodilation and will enhance delivery/transport of Oxygen/CO2 to cells
🧬 Each hemoglobin molecule contains 4 heme rings [4]
Hemoglobin
📊 Normal Hemoglobin Levels:
♂ Male: 13-18 g/dL
♀ Female: 12-16 g/dL
🌬 Transports Oxygen (O₂) & Carbon Dioxide (CO₂)
🩸 Oxygen enters hemoglobin for circulation.
💨 Carbon dioxide binds with hemoglobin for removal.
⚖ Maintains blood pH for balance.
🔄 Releases Nitric Oxide (NO) → Vasodilation for proper blood flow.
✅ True! 🚨 Elevated methemoglobin levels reduce oxygen delivery, leading to serious health issues.
💡 True or False: Methemoglobin does not effectively bind oxygen, and levels higher than 2% can cause hypoxia, cyanosis, and potentially lead to death (methemoglobinemia).

🚨 Methemoglobinemia (Abnormal Hemoglobin Condition)
🔄 Iron in hemoglobin changes from Ferrous (Fe²⁺) to Ferric (Fe³⁺) form.
❌ Does not effectively bind oxygen, reducing oxygen transport.
📉 Normal methemoglobin levels: <2%. Higher levels cause:
😲 Hypoxia (low oxygen levels)
🔵 Cyanosis (bluish skin discoloration)
☹ Headache
👿 Dizziness
✅ Answer: C. Transferrin – It is a serum protein made in the liver, responsible for binding and transporting iron.
❌ False! – Ferrous iron (Fe²⁺) must be oxidized to Ferric iron (Fe³⁺) by ferroxidase for transport.
✅ Answer: B. Liver – Transferrin is a serum protein synthesized in the liver to transport iron.
✅ True! – Transferrin binds ferric iron (Fe³⁺) tightly to deliver it to cells safely.
❓ 1. Which protein is responsible for transporting iron in the blood?
A. Ferritin
B. Hemoglobin
C. Transferrin
D. Myoglobin
💡 2. True or False: Ferrous iron (Fe²⁺) is the preferred form for iron transport in the blood.
❓ 3. Where is transferrin primarily produced?
A. Bone marrow
B. Liver
C. Kidneys
D. Spleen
💡 4. True or False: Transferrin has the highest affinity for iron, ensuring efficient transport.
Methemoglobinemia (at a level of 70% is lethal)
😲 Condition where there is greater than the normal level of methomoglobin
🩸 Iron Transport in Blood
🏗 Iron is transported in the blood bound to transferrin (only in the ferric state Fe³⁺).
🔄 Ferrous Iron (Fe²⁺) is oxidized by ferroxidase (Hephaestin) during transport via ferroportin.
🛠 Transferrin (Iron-Binding Protein)
🏭 Produced in the liver – Major serum protein for iron transport.
🎯 Highest affinity for Ferric Iron (Fe³⁺) – Ferrous Iron (Fe²⁺) does not bind to transferrin.
🔗 Can bind to 2 ferric iron (Fe³⁺) molecules.
🩸 Heme Breakdown
🟢 Heme → Biliverdin (green pigment produced by heme oxygenase).
🟠 Biliverdin → Bilirubin (orange pigment, further processed in the liver).
💉 RBC Life Cycle
READ NLNG, this was from ‘22 trans

Negative feedback
📊 Negative Feedback Response:
🏥 Triggers erythropoietin (EPO) release to stimulate RBC production in the bone marrow.
🔄 Restores oxygen levels and prevents further syncope.
📌 A regulatory mechanism that responds to decreased erythropoiesis (RBC production).
⚠ Effect of Low RBC Production:
📉 Reduced oxygen (O₂) delivery to tissues.
🧠 Symptom: Temporary syncope (fainting) due to lack of oxygen in the brain.
Reticulocyte Count
Hematocrit
Mean Corposcular Volume (MCV)
Mean Cell Hemoglobin (MCH)
Mean Corpouscualr Hemoglobin Concentration (MCHC)
Red Blood Cell Distribution Width (RDW)
Erythrocyte Sedimentation Rate
Pregancy Tests
🩸📊 Blood Laboratory Tests [8]

Reticulocyte Count 🩸
[🩸📊 What Blood Laboratory Test?]
📌 A test that measures the percentage of reticulocytes (immature RBCs) in the blood.
🩺 Determines the rate of erythropoiesis (RBC production).
📊 Normal Range: 0.5% – 1.5% of total blood cells.
⚠ Abnormal Results:
📉 Reticulocytopenia (Low Count) – Indicates reduced RBC production.
📈 Reticulocytosis (High Count) – May indicate:
🩸 Bleeding
🩺 Anemia
⚠ Kidney disease
🍽 Vitamin B deficiency
✅ Answer: C. Percentage of immature RBCs in the blood – The reticulocyte count determines the rate of erythropoiesis.
✅ True! 📉 Lower erythropoiesis = Fewer reticulocytes in circulation.
✅ Answer: D. All of the above – High reticulocyte count may indicate bleeding, anemia, kidney disease, or vitamin B deficiency.
✅ True! 📊 This is the standard range for healthy erythropoiesis.
❓ 1. What does a reticulocyte count measure?
A. White blood cell production
B. Platelet function
C. Percentage of immature RBCs in the blood
D. Blood clotting time
💡 2. True or False: A decreased rate of erythropoiesis leads to a lower number of reticulocytes in the blood.
❓ 3. Which of the following conditions may cause reticulocytosis (high reticulocyte count)?
A. Bleeding
B. Anemia
C. Kidney disease
D. All of the above
💡 4. True or False: A normal reticulocyte count ranges from 0.5% – 1.5% of total blood cells.

Hematocrit 🩸📊
[🩸📊 What Blood Laboratory Test?]
📌 A test that measures the percentage of RBCs in the blood.
📊 Normal Values:
♂ Males: 38.8% – 48.6%
♀ Females: 35.5% – 44.9%
⚠ Abnormal Results:
📉 Low Hematocrit (Anemia) – Indicates insufficient RBCs.
📈 High Hematocrit (Polycythemia, >65%) – May indicate excess RBC production, leading to thicker blood and potential complications.
✅ Answer: B. Red blood cell percentage in blood – Hematocrit measures how much of the blood is composed of RBCs
✅ True! 📈 Polycythemia occurs when the RBC percentage is too high, which can lead to thicker blood and circulation issues.
✅ Answer: C. 42% – The normal range for males is 38.8% – 48.6%.
✅ True! 📉 Anemia is characterized by a low percentage of RBCs, leading to reduced oxygen delivery in the body.
❓ 1. What does the hematocrit test measure?
A. White blood cell percentage in blood
B. Oxygen saturation
C. Platelet function
D. Red blood cell percentage in blood
💡 2. True or False: A hematocrit value above 65% is considered polycythemia.
❓ 3. Which of the following hematocrit values is considered normal for a healthy male?
A. 25%
B. 32%
C. 42%
D. 68%
💡 4. True or False: Low hematocrit levels indicate anemia.

Mean Corposcular Volume (MCV) 🩸📏
[🩸📊 What Blood Laboratory Test?]
📌 Determines the average size of RBCs.
📐 Unit of Measurement – Femtoliters (fL).
Results
📉 Microcytic – Low RBC size.
✅ Normocytic – Normal size (80-100 fL).
📈 Macrocytic – High RBC size.
✅ Answer: C. Mean Corpuscular Volume (MCV) – MCV measures RBC size and classifies them as microcytic, normocytic, or macrocytic.
❓ Which blood test determines the average size of RBCs and is measured in femtoliters (fL)?
A. Mean Corpuscular Hemoglobin (MCH)
B. Hematocrit (Hct)
C. Mean Corpuscular Volume (MCV)
D. Red Blood Cell Distribution Width (RDW)

🛑 Anisocytosis (RBC Size Variation)
🔄 Condition where RBCs have unequal sizes.
🩸 Blood may contain both microcytic and macrocytic RBCs.
🩸📊 Mean Cell Hemoglobin (MCH)
[🩸📊 What Blood Laboratory Test?]
📌 Measures the average amount of hemoglobin per red blood cell
Formula: MCH = Hgb/RBC count (millions)
📊 Normal Value: 27 - 31 picograms (pg) per cell.
✅ Answer: B. The average amount of hemoglobin per RBC – MCH helps determine how much hemoglobin is present in each red blood cell.
❓ What does the MCH test measure?
A. The total number of RBCs in the blood
B. The average amount of hemoglobin per RBC
C. The percentage of hemoglobin in the blood
D. The average size of RBCs
Mean Corpuscular Hemoglobin Concentration (MCHC) 🩸📊
📌 Importance – Helps classify anemia types based on hemoglobin saturation in RBCs.
[🩸📊 What Blood Laboratory Test?]
📌 measures the amount of hemoglobin per volume of RBCs.
Results
📉 Hypochromic – Low hemoglobin concentration.
✅ Normochromic – Normal hemoglobin concentration (32 - 36 g/dL).
🔴 Hyperchromic – High hemoglobin concentration, RBCs appear darker with no white center.
Normal values range from 32-36 grams/dL
![<p><strong>[</strong><span data-name="drop_of_blood" data-type="emoji">🩸</span><span data-name="bar_chart" data-type="emoji">📊</span> <strong>What Blood Laboratory Test?]</strong></p><ul><li><p><span data-name="pushpin" data-type="emoji">📌</span> measures the <strong>amount of hemoglobin per volume of RBCs</strong>.</p></li><li><p class="has-focus">Results</p><ul><li><p class="has-focus"><span data-name="chart_decreasing" data-type="emoji">📉</span> <strong>Hypochromic</strong> – Low hemoglobin concentration.</p></li><li><p><span data-name="check_mark_button" data-type="emoji">✅</span> <strong>Normochromic</strong> – Normal hemoglobin concentration (32 - 36 g/dL).</p></li><li><p><span data-name="red_circle" data-type="emoji">🔴</span> <strong>Hyperchromic</strong> – High hemoglobin concentration, RBCs appear darker with no white center.</p></li></ul></li><li><p class="has-focus">Normal values range from 32-36 grams/dL</p></li></ul><p></p>](https://knowt-user-attachments.s3.amazonaws.com/59fa6969-9755-4d62-8362-97276ece5041.png)
✅ True! 🩸
💡 True or False: Anemia in general is defined based on cell size (MCV) 📏 and amount of hemoglobin (MCH) 💉.
Red Blood Cell Distribution Width (RDW) 🩸📊
[🩸📊 What Blood Laboratory Test?]
📌 Measures the variation in RBC size in a blood sample.
🛠 Purposes:
📏 Assesses RBC size variation.
🩺 Diagnose and classify anemias.
📊 Results:
✅ Normal Range: 10.5% – 15%.
⚠ Anisocytosis – Increased RDW, indicating a wide variation in RBC size.
✅ Answer: D. The variation in RBC size – RDW helps assess the degree of size differences among RBCs in a blood sample.
😲 False! A normal RDW range is 10.5% – 15%.
✅ Answer: C. Wide variation in RBC sizes – Anisocytosis refers to abnormal RBC size differences, often linked to anemia.
❓ 1. What does the RDW test measure?
A. The average size of RBCs
B. The amount of hemoglobin in RBCs
C. The number of RBCs in the blood
D. The variation in RBC size
💡 2. True or False: A normal RDW range is 10.5% – 20%.
❓ 3. An increased RDW value (anisocytosis) may indicate:
A. Normal RBC size
B. A decrease in RBC count
C. Wide variation in RBC sizes
D. Increased oxygen-carrying capacity

Anisocytosis 🩸🔬
📌 A condition where RBCs have irregular sizes or circumferences.
🔄 Variation in RBC size, leading to an uneven distribution in a blood sample.
Poikilocytosis 🩸🔬
📌 A condition where RBCs exhibit abnormal shapes in a blood sample.

🌵 Acanthocytes
Thorn like projects coming out of the RBCs
🎯 Codocytes
Darkly stained central
💧 Dacrocytes
Pear-shaped or tear drop-shaped
🌙 Drepanocytes
Sickle cells
☀ Echinocytes
Short thorn-like projections
🏈 Elliptocytes
Elliptical in shape
📊 Types of Poikilocytes in RBCs [6]

Erythrocyte Sedimentation Rate (ESR) 🩸📉
[🩸📊 What Blood Laboratory Test?]
📌 Also Known As Sedimentation Rate
🩺 A blood test that measures how fast RBCs settle at the bottom of a vertical tube over time without utilizing a blood centrifuge
🚫 Does not use a centrifuge – The separation rate is monitored naturally.
🛑 Used as a screening test for inflammatory conditions, autoimmune diseases, or cancer.
❌ Not a diagnostic test – It only indicates the presence of inflammation, not the exact cause.
📊 Normal ESR Values:
♂ Males: <20 mm/hr
♀ Females: <30 mm/hr
❌ False! 🚫 ESR does not use a centrifuge; the natural settling rate of RBCs is monitored.
✅ Answer: B. Diagnosing a specific disease – ESR cannot diagnose a disease, only indicate the presence of inflammation.
✅ True! 📊 These are the standard reference values for a normal ESR test.
💡 1. True or False: The Erythrocyte Sedimentation Rate (ESR) test uses a centrifuge to separate RBCs.
❓ 2. Which of the following is NOT a use of the ESR test?
A. Screening for inflammation
B. Diagnosing a specific disease
C. Detecting autoimmune conditions
D. Monitoring cancer progression
💡 3. True or False: The normal ESR value for males is <20 mm/hr, and for females, it is <30 mm/hr.
Pregnancy Test (Other test)
[🩸📊 What Blood Laboratory Test?]
📌A test that detects the presence of human chorionic gonadotropin (hCG) hormone in the blood.
🎯 More sensitive than urine pregnancy tests.
⏳ Can detect pregnancy 6-8 days after ovulation.
🏥 Used less often compared to home urine tests but provides earlier and more accurate results.
✅ Answer: C. Human Chorionic Gonadotropin (hCG) – hCG is produced during pregnancy and detected in blood tests.
❌ False! 🩸 Blood tests are more sensitive and can detect pregnancy 6-8 days after ovulation, earlier than urine tests.
✅ Answer: A. It is more expensive and requires a lab test. – While more accurate, blood pregnancy tests are less commonly used due to cost and lab requirements.
❓ 1. What hormone does the blood pregnancy test detect?
A. Estrogen
B. Progesterone
C. Human Chorionic Gonadotropin (hCG)
D. Luteinizing Hormone (LH)
💡 2. True or False: A blood pregnancy test is less sensitive than a home urine pregnancy test.
❓ 3. Why is the blood pregnancy test used less often than the urine test?
A. It is more expensive and requires a lab test.
B. It is less accurate than urine tests.
C. It takes longer to detect pregnancy.
D. It cannot detect hCG levels.
Anemia 🩸⚠
[ERYTHROCYTES DISORDER🩸]
📌 A condition where the blood has reduced oxygen-carrying capacity.
📊 Classification Based On:
📏 Cell Size: Microcytic, Normocytic, Macrocytic (Test: MCV)
💉 Hemoglobin Content: Low hemoglobin levels (Test: MCH)
🔍 Causes:
📉 Reduced RBC count.
⚠ Decreased hemoglobin (Hgb) levels in the blood.
🛑 Symptoms:
😴 Fatigue (most common).
❄ Intolerance to cold (low oxygen → low ATP & heat production).
🏳 Paleness (due to low hemoglobin levels).
📌 ATP Connection:
⚡ Oxygen is needed for ATP production.
🔥 Low ATP = Less heat, leading to fatigue & cold intolerance
✅ Answer: C. Mean Corpuscular Volume (MCV) – MCV determines whether RBCs are microcytic, normocytic, or macrocytic.
😲 True! 🩸 Anemia results from low RBC count or decreased hemoglobin, reducing oxygen transport.
✅ Answer: B. Fatigue – Anemia reduces oxygen and ATP production, leading to tiredness.
✅ True! ❄ Oxygen is needed for ATP generation, which produces heat. Low oxygen = feeling cold.
✅ Answer: C. High blood glucose levels – Anemia is caused by low RBC count or hemoglobin, not glucose levels.
❓ 1. What laboratory test is used to determine RBC size in anemia classification?
A. Mean Corpuscular Hemoglobin (MCH)
B. Hematocrit (Hct)
C. Mean Corpuscular Volume (MCV)
D. Erythrocyte Sedimentation Rate (ESR)
💡 2. True or False: Anemia is defined as a reduced oxygen-carrying capacity of the blood.
❓ 3. What is the most common symptom of anemia?
A. Fever
B. Fatigue
C. Swelling
D. High blood pressure
💡 4. True or False: Anemia can cause intolerance to cold due to reduced ATP and heat production.
❓ 5. Which of the following is NOT a direct cause of anemia?
A. Reduced number of RBCs
B. Decreased hemoglobin levels
C. High blood glucose levels
D. Low oxygen-carrying capacity of blood
Iron-Deficiency Anemia (IDA) 🩸
[ERYTHROCYTES DISORDER🩸]
📌 Caused by inadequate iron absorption or excessive iron loss.
🌍 Most prevalent type of anemia worldwide.
🔬 Microcytic, hypochromic anemia (small, pale RBCs).
🩸 Normal blood smear: Normocytic, normochromic in early stages.
🥩 Best Dietary Sources of Iron:
🍖 Meat (rich in heme iron).
🌿 Malunggay (Moringa) – Plant-based iron source.
⚠ Common Causes:
🥗 Vegetarians – Lack of iron-rich meats in diet.
🤰 Pregnant Women – Higher iron demand for baby.
🩸 Menstruation – Heavy blood flow = high iron loss.
💉 Frequent Blood Donation – Reduces blood and iron levels.
Pernicious Anemia 🩸
[ERYTHROCYTES DISORDER🩸]
📌Caused by the inability of the stomach to produce intrinsic factor (IF), leading to Vitamin B12 deficiency.
❌ Intrinsic Factor (IF) is required for Vitamin B12 absorption in the small intestine (terminal ileum).
💉 Vitamin B12 is essential for RBC production – No IF → No Vitamin B12 Absorption → Low RBC Production → Pernicious Anemia.
🔬 Macrocytic/Megaloblastic Anemia – Enlarged, immature RBCs due to impaired DNA synthesis.
⚠ Common Causes:
🥩 Vitamin B12 Deficiency (dietary or absorption issues).
🏥 Liver Disease – Affects vitamin storage/metabolism.
🏋 Malabsorption Disorders (e.g., Crohn’s disease).
🍷 Excessive Alcohol Use – Impairs nutrient absorption.
🩸 Pernicious Anemia – Autoimmune destruction of gastric parietal cells, leading to IF deficiency.
🦋 Hypothyroidism – Can contribute to decreased RBC production.
✅ Answer: B. Lack of intrinsic factor (IF) – Intrinsic factor is necessary for Vitamin B12 absorption, and without it, RBC production decreases.
✅ True! 🔬 Pernicious anemia leads to enlarged, immature RBCs due to Vitamin B12 deficiency.
✅ Answer: D. Stomach – Intrinsic factor is produced by gastric parietal cells in the stomach.
❌ False! ➡ Vitamin B12 is absorbed in the terminal ileum of the small intestine, but it requires intrinsic factor from the stomach for transport.
✅ Answer: D. High iron intake – Pernicious anemia is caused by Vitamin B12 deficiency, not iron levels.
❓ 1. What is the main cause of pernicious anemia?
A. Iron deficiency
B. Lack of intrinsic factor (IF)
C. Low platelet count
D. Excessive blood loss
💡 2. True or False: Pernicious anemia is a macrocytic (megaloblastic) anemia, meaning RBCs are larger than normal.
❓ 3. Which organ's dysfunction leads to intrinsic factor deficiency?
A. Liver
B. Bone marrow
C. Kidneys
D. Stomach
💡 4. True or False: Vitamin B12 absorption occurs in the stomach.
❓ 5. Which of the following is NOT a common cause of pernicious anemia?
A. Vitamin B12 deficiency
B. Liver disease
C. Malabsorption
D. High iron intake
🩸 Hemorrhagic Anemia
[ERYTHROCYTES DISORDER🩸]
📌 Caused by excessive RBC loss due to bleeding.
🛑 Types:
🚨 Acute – Sudden, heavy bleeding from:
🔪 Large wounds.
🩸 Heavy menstrual bleeding.
⏳ Chronic – Slow, prolonged bleeding from:
🏥 Stomach ulcers.
Hemolytic Anemia
[ERYTHROCYTES DISORDER🩸]
📌 Premature destruction (rupture) of RBCs before their normal lifespan ends.
🛑 Causes:
🧬 Inherent defects (genetic disorders affecting RBC shape).
☠ Toxins (e.g., chemicals, drugs).
🦠 Parasites (e.g., Malaria damages RBCs).
💉 Antibodies from incompatible blood transfusions (immune system attacks foreign RBCs).
📌 Distorted RBC shapes make them fragile and prone to destruction.
✅ Answer: B. Excessive loss of RBCs through bleeding – Hemorrhagic anemia occurs when RBCs are lost due to heavy or prolonged bleeding.
❌ False! ⏳ Chronic hemorrhagic anemia occurs due to slow, prolonged bleeding, such as from stomach ulcers.
✅ Answer: A. Blood transfusion reaction – Hemolytic anemia can occur when antibodies attack RBCs in an incompatible transfusion.
✅ True! 🦠 Parasites (like malaria), toxins, and inherited RBC defects can all lead to premature RBC destruction.
✅ Answer: C. Hemolytic anemia – Hemolytic anemia occurs when RBCs rupture prematurely, reducing their oxygen-carrying capacity.
❓ 1. What is the primary cause of hemorrhagic anemia?
A. Premature RBC destruction
B. Excessive loss of RBCs through bleeding
C. Lack of intrinsic factor (IF)
D. Deficiency of Vitamin B12
💡 2. True or False: Chronic hemorrhagic anemia is caused by sudden and heavy bleeding from large wounds or injuries.
❓ 3. Which of the following is a cause of hemolytic anemia?
A. Blood transfusion reaction
B. Iron deficiency
C. Loss of RBCs through bleeding
D. Low platelet count
💡 4. True or False: Hemolytic anemia can be caused by parasites, toxins, and genetic defects.
❓ 5. Which type of anemia involves RBC rupture before their normal lifespan ends?
A. Hemorrhagic anemia
B. Pernicious anemia
C. Hemolytic anemia
D. Aplastic anemia
Hemolytic Disease of the Newborn (Erythroblastosis fetalis) 🩸👶
📌 Also Known As – Erythroblastosis fetalis.
🛑 Occurs when
🩸 Incompatible blood type between mother & baby.
⚠ Rh factor is a protein that can be found on the surface of RBCs
✅ Rh-positive (e.g., O⁺) – Has Rh protein.
❌ Rh-negative (e.g., A⁻) – Lacks Rh protein.
🦠Autoimmune disorder condition where the RBCs of the fetus are being targeted and lysed by the mother’s antibodies
👩👦 If the baby’s Rh-positive blood enters an Rh-negative mother, the mother’s immune system sees it as foreign.
🛡 Mother creates antibodies to attack fetal RBCs, leading to RBC destruction (lysis).
⚠ Complications:
🔄 RBC destruction → Anemia, jaundice, organ damage.
🚨 Can range from mild to severe conditions.
🤰 During the first pregnancy, the mother’s immune system becomes sensitized (creates antibodies).
🔄 In a second or later pregnancy, the antibodies attack the baby’s RBCs more aggressively.
⚠ Can also occur after miscarriage or abortion.
📌 Why Hemolytic Disease of the Newborn (HDN) Happens in the 2nd Pregnancy 🩸👶
✅ Answer: B. Erythroblastosis fetalis – HDN is caused by Rh incompatibility between the mother and baby.
❌ False! ❌ – HDN occurs when an Rh-negative mother carries an Rh-positive baby, leading to an immune response against fetal RBCs.
✅ Answer: B. The mother's immune system produces antibodies against it. – The body sees the fetal RBCs as foreign and creates antibodies to destroy them.
❌ False! 🔄 – The first pregnancy sensitizes the mother, but HDN is more severe in the second or subsequent pregnancies when the mother already has antibodies.
✅ Answer: D. All of the above – HDN risk increases if the mother has been previously exposed to Rh-positive blood, even from miscarriage or abortion.
❓ 1. What is another name for Hemolytic Disease of the Newborn (HDN)?
A. Erythroblastosis fetalis
B. Pernicious anemia
C. Iron-deficiency anemia
D. Megaloblastic anemia
💡 2. True or False: HDN is more common when an Rh-positive mother carries an Rh-negative baby.
❓ 3. What happens if fetal Rh-positive blood enters an Rh-negative mother's bloodstream?
A. The mother's immune system ignores it.
B. The mother's immune system produces antibodies against it.
C. The mother’s blood cells start attacking themselves.
D. The baby’s immune system attacks its own RBCs.
💡 4. True or False: Hemolytic Disease of the Newborn (HDN) is more severe in the first pregnancy.
❓ 5. HDN can also occur after:
A. Miscarriage
B. Abortion
C. A previous Rh-incompatible pregnancy
D. All of the above.
Hydrops Petals 🩸👶
📌 A serious, life-threatening condition where there is abnormal fluid accumulation in two or more fetal compartments.
🛑 Effects:
💧 Severe swelling (edema) in the fetus.
Occurs during pregnancy and poses a high risk to the health and survival of the fetus
🏥 Interferes with organ function, increasing risk of death shortly after birth.
🩸 1. Immune Causes
🔄 Rh incompatibility (most common immune cause).
Will lead to Hemolytic Disease of the Newborn (HDN)
🔬 Blood group incompatibilities.
🛡 Antibody reactions attacking fetal RBCs
🦠 2. Non-Immune Causes –
🧬 Genetic disorders.
🦠 Infections (e.g., Parvovirus B19).
🏗 Structural abnormalities.
🔥 Metabolic disorders.
💔 Cardiac abnormalities affecting circulation.
🩸👶 Causes of Hydrops Fetalis: [2]

Thalassemias 🧬
📌 A group of genetic blood disorders causing abnormal hemoglobin production, leading to anemia.
🧬 Cause:
⚠ Gene mutations affect hemoglobin synthesis.
❌ Defect or absence of genes responsible for alpha- or beta-globin chain production.
🔄 Results in premature RBC death
😲 Result: Reduced or absent synthesis of one or more of its components
📊 Characteristics:
📉 Microcytic, hypochromic RBCs (small & pale).
⏳ Short RBC lifespan → Chronic anemia.
🩸 Regular blood transfusions to maintain normal hemoglobin levels.
💉 Treatment for THALASSEMIAS
𝛃 (Beta) Thalassemia – Defective or missing beta-globin chains.
𝛂 (Alpha) Thalassemia – Defective or missing alpha-globin chains.
📌 Types of Thalassemia: [2]
𝛃 (Beta) Thalassemia
𝛃 Thalassemia Minor – Only 1 defective gene, mild symptoms.
𝛃 Thalassemia Major – Both genes are defective, severe anemia, requires lifelong transfusions.
[Types of Thalassemia]
📌 Defective or missing beta-globin chain synthesis.
📍 Located in chromosomes, controlled by 2 genes.
𝛂 (Alpha) Thalassemia
Secret Carrier – 1 defective gene, no symptoms.
𝛂 Thalassemia Minor – 2 defective genes, mild anemia.
Hb H Disease – 3 defective genes, moderate to severe anemia.
Hydrops Fetalis – All 4 genes defective, fatal condition, as alpha chains are needed for fetal hemoglobin (HbF) synthesis.
[Types of Thalassemia]
📌 Definition – Defective or missing alpha-globin chain synthesis.
📍 Controlled by 4 genes.
✅ Answer: A. A defect or absence of beta-globin chain synthesis – Beta-thalassemia occurs when beta-globin chains are missing or defective.
❌ False! 🚨 Beta Thalassemia Major occurs when both genes are defective, leading to severe anemia requiring lifelong blood transfusions.
✅ Answer: C. 4 – Four genes control alpha-globin chain synthesis, and different mutations determine disease severity.
✅ True! ⚠ Without alpha chains, fetal hemoglobin (HbF) cannot be produced, leading to fetal death.
✅ Answer: B. Silent Carrier – Only one defective gene, so the person has no symptoms or mild anemia.
❓ 1. What causes Beta (𝛃) Thalassemia?
A. A defect or absence of beta-globin chain synthesis
B. A lack of intrinsic factor (IF)
C. Iron deficiency
D. A defect in platelet production
💡 2. True or False: In 𝛃 (Beta) Thalassemia Major, only one gene is defective, leading to mild anemia.
❓ 3. How many genes control Alpha (𝛂) Thalassemia?
A. 2
B. 3
C. 4
D. 6
💡 4. True or False: Hydrops Fetalis (the most severe form of Alpha Thalassemia) results from all four defective alpha genes
❓ 5. Which of the following is a mild form of Alpha (𝛂) Thalassemia?
A. Hydrops Fetalis
B. Silent Carrier
C. Hb H Disease
D. Beta Thalassemia Major
D. Both statements are false.
Thalassemia is characterized by the reduced or absence of RBC components. In contrast, anisocytosis has complete RBC components but RBCs vary in size.
I. Anisocytosis is characterized by the reduced or absence of RBC components.
II. In contrast, Thalassemia has complete RBC components but RBCs vary in size.
A. The first statement is true. The second statement is false.
B. The first statement is false. The second statement is true.
C. Both statements are true.
D. Both statements are false.

Aplastic Anemia 🩸
📌 A rare but serious blood disorder where the bone marrow fails to produce all types of blood cells.
🧬 Stem cells
🔴 Red Blood Cells (RBCs) → Leads to anemia.
⚪ White Blood Cells (WBCs) → Increases infection risk.
🩸 Platelets → Causes bleeding issues.
⚠ Pancytopenia
🚨 Causes:
☠ Toxins (e.g., chemicals, environmental exposure).
☢ Radiation therapy.
💉 Chemotherapy.
🩺 Treatment:
🏥 Bone marrow transplant with immunosuppressive therapy.
❌ False! ⚠ Pancytopenia is not a disease itself, but a symptom of bone marrow failure in conditions like aplastic anemia.
✅ Answer: D. All of the above – Aplastic anemia affects all major blood cell types, leading to anemia, infections, and bleeding problems.
😲 True !
✅ Answer: C. Bone marrow transplant with immunosuppression – This helps restore blood cell production by replacing damaged bone marrow.
💡 1. True or False: Pancytopenia is a disease that specifically causes aplastic anemia.
❓ 2. Which of the following blood cell types is affected in aplastic anemia?
A. Red blood cells (RBCs)
B. White blood cells (WBCs)
C. Platelets
D. All of the above
💡 3. True or False: Radiation therapy and chemotherapy are potential causes of aplastic anemia.
❓ 4. What is a common treatment for aplastic anemia?
A. Iron supplements
B. Bloodletting
C. Bone marrow transplant with immunosuppression
D. Vitamin B12 injections
Pancytopenia
😲 A condition where all three major blood cell types are significantly reduced. It is a symptom of bone marrow failure, not a disease itself.

Sickle Cell Anemia
📌 A genetic blood disorder where abnormal hemoglobin (Hgb-S) causes RBCs to become sickle-shaped.
🔬 are stiff & rod-like, leading to:
🚨 Easily ruptured cells → Hemolytic anemia.
🚧 Blood vessel obstruction → Tissue damage.
⏳ Reduced lifespan (<20 days) compared to normal RBCs (120 days).
🦠 Cause – Inherited Disorder:
🧬 SCA gene provides resistance to malaria.
🧩 Heterozygous (Sickle Cell Trait) → Partial protection against malaria due to potassium leakage killing parasites.
⚠ Homozygous (Sickle Cell Anemia) → Severe disease, highly susceptible to malaria deaths.
⚠ Symptoms:
🦶 Hand-Foot Syndrome (children) → Swelling in feet & wrists.
🩸 Pain in limbs & back (elderly) due to blocked blood flow.
🩺 Treatment:
💊 Analgesics for pain relief.
💉 Antibiotics to prevent infections.
🩸 Blood transfusions to replace damaged RBCs.
😲 Symptoms [2] and Treatment [3] for Sickle Cell Anemia
HbA or HbA1
95-98% in healthy adults
HbA2
2-3% in healthy adults
HbF
50-80% in newborn
Gradually declines throughout a person’s lifetime (HbA1 becomes most prevalent)
Normal Hemoglobin Types 🩸🧬 [3]
🧪 Hemoglobin S (HbS) Mutation:
🔬 Mutation in the 6th position of the beta-globin chain.
⚠ Glutamic acid (normal) is replaced by valine → Causes sickle-shaped RBCs.
✅ HbAS (Sickle Cell Trait)
🧬 Heterozygous - Only one beta-globin chain is mutated.
⚠ Asymptomatic (no sickle cell disease).
⏳ Normal lifespan
🚨 HbSS (Sickle Cell Anemia)
🧬 Homozygous – Both beta-globin chains are mutated.
🩸 Exhibits symptoms of anemia (pain, fatigue, organ damage).
📉 Shortened RBC lifespan & higher risk of complications.
🛑 Types of HbS Mutations
HbAS
[Type of HbS?]
mutation in only one beta globin chain, asymptomatic
HbSS
[Type of HbS?]
mutation occurs in both beta globin chains

Polycythemia 🩸📈
📌A condition where there is an abnormally high RBC count in circulation.
📉 Hematocrit >65%
🛑 Effects:
🩸 Increased blood viscosity → Thicker blood.
📈 Increased blood pressure (BP) → Higher strain on the heart.
🚨 Thrombosis (Blood Clots) → Too many RBCs pile up in small blood vessels, increasing clot risk.
C. Both statements are true.
I. Polycythemia is the abnormal increase in circulating RBC count
II. Hyperemia is the unusual amount of blood in an organ
A. The first statement is true. The second statement is false.
B. The first statement is false. The second statement is true.
C. Both statements are true.
D. Both statements are false.
A. The first statement is true. The second statement is false.
II. They do not contain Hgb
I. Leukocytes are the only complete cells in the blood
II. Leukocytes usually contain Hgb
A. The first statement is true. The second statement is false.
B. The first statement is false. The second statement is true.
C. Both statements are true.
D. Both statements are false.

Leukocytes (WBCs) ⚪🩸
Also known as white blood cells (WBCs), they are the only complete cells in the blood.
🧬 Key Features:
❌ Do not contain hemoglobin (Hgb).
📊 Make up <1% of total blood volume.
🔬 Normal WBC Count: 5,000 - 10,000/mm³.
🩸 Lifespan:
⏳ Most WBCs live for a few hours to a few days.
🛡 T & B memory cells can live for years
🔹 Granulocytes
🔹 Agranulocytes
📌 Two Main Types of Leukocytes (WBCs):
🔹 Granulocytes
🔬 Contain granules in cytoplasm that release substances for immune defense.
🛡 Fight infections & inflammation.
🏆 Examples:
Neutrophils – Most abundant, first responders to infections.
Eosinophils – Involved in allergic reactions & parasitic infections.
Basophils – Release histamine, play a role in allergic responses.
🔹 Agranulocytes
🔬 Lack visible granules in cytoplasm, giving a smoother appearance under a microscope.
🏆 Examples:
Lymphocytes – Most abundant agranulocyte, crucial for adaptive immunity (B & T cells).
Monocytes – Become macrophages to engulf pathogens & dead cells.
B. The first statement is false. The second statement is true.
I. Agranulocytes have a smoother appearance under a microscope
I. Granulocytes have a smoother appearance under a microscope
II. Agranulocytes lack visible granules in their cytoplasm
A. The first statement is true. The second statement is false.
B. The first statement is false. The second statement is true.
C. Both statements are true.
D. Both statements are false.
Leukemia
An abnormal increase in WBC count
Acute Leukemia
Rapid onset & progression, uncontrolled production of immature WBCs.
🔴 Acute Lymphoblastic Leukemia (ALL)
Type of Acute Leukemia
Affects lymphoid cells.
👶 More common in children.
⚡ Progresses rapidly.
🩸 Acute Myeloid Leukemia (AML
Type of Acute Leukemia
Affects myeloid cells.
Occurs in both children & adults.
⚡ Rapid disease progression.